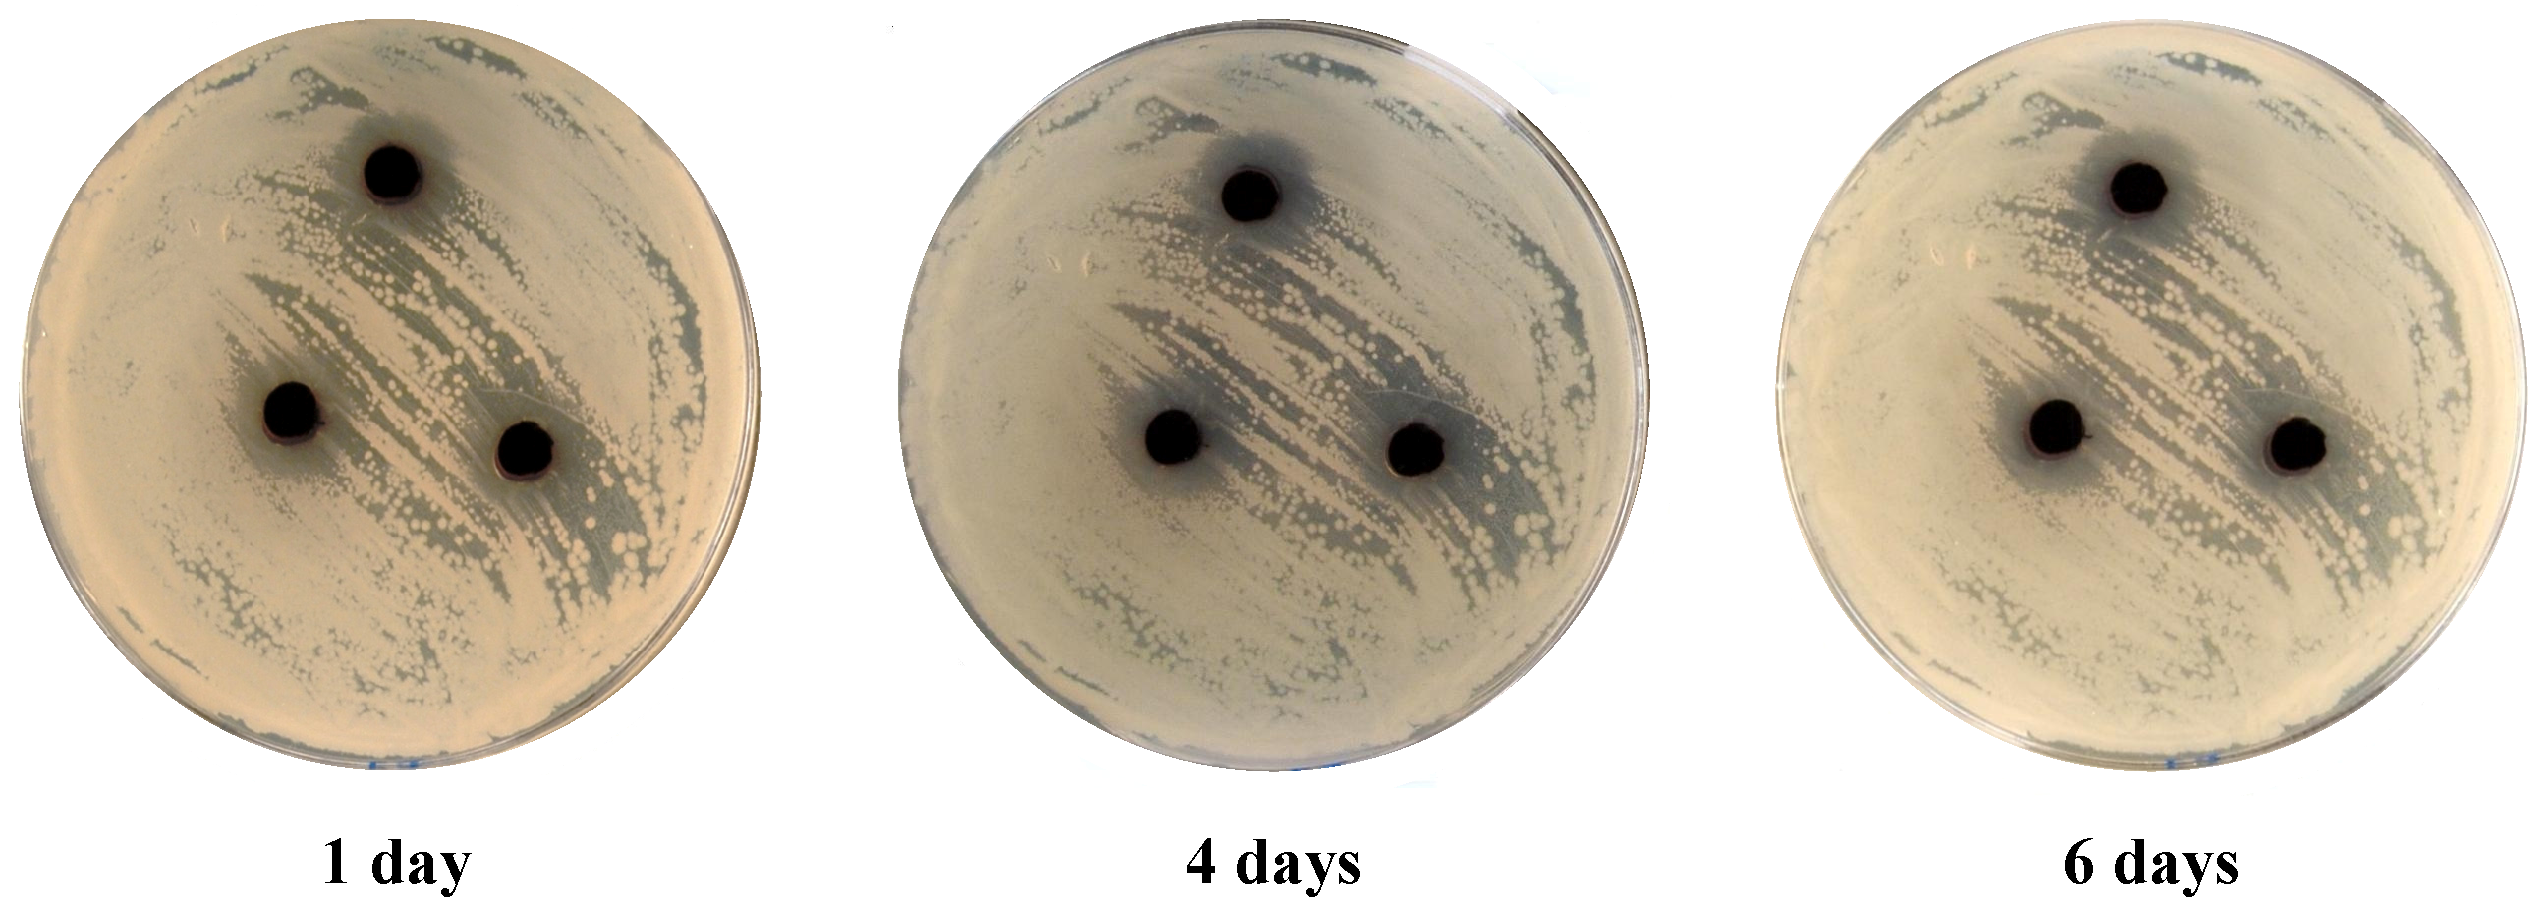

Disperse Dyes Based on Aminothiophenes: Their Dyeing Applications on Polyester Fabrics and Their Antimicrobial Activity
Abstract
:1. Introduction
2. Results and Discussion
2.1. Synthesis
2.2. Dyeing



| Dye No. | Color on polyester
(2% shade) | L* | a* | b* | C* | h* | K/S |
|---|---|---|---|---|---|---|---|
| 3 | Yellowish-brown | 50.77 | 4.40 | 20.70 | 21.17 | 78.01 | 13.33 |
| 4 | Brown | 46.06 | 24.84 | 29.03 | 38.21 | 49.45 | 17.78 |
| 7 | Cream | 83.98 | 11.31 | 42.49 | 43.97 | 75.09 | 6.79 |
| 8 | Light brown | 68.84 | 22.97 | 39.59 | 45.77 | 59.88 | 10.49 |
| 9 | Brownish-yellow | 66.03 | 22.50 | 60.44 | 64.49 | 69.58 | 16.30 |
| 11 | Light cream | 82.96 | 9.55 | 33.54 | 34.87 | 74.11 | 6.76 |
| Dye No. | Wash fastness | Perspiration fastness | Light fastness | |||||||
|---|---|---|---|---|---|---|---|---|---|---|
| Alkaline | Acidic | |||||||||
| Alt | SC | SW | Alt | SC | SW | Alt | SC | SW | ||
| 3 | 5 | 5 | 5 | 5 | 5 | 5 | 5 | 5 | 5 | 2 |
| 4 | 5 | 5 | 5 | 5 | 4–5 | 5 | 5 | 5 | 5 | 2 |
| 7 | 5 | 5 | 5 | 5 | 5 | 5 | 5 | 5 | 5 | 6 |
| 8 | 5 | 4–5 | 5 | 5 | 4–5 | 5 | 5 | 4–5 | 5 | 3 |
| 9 | 5 | 5 | 5 | 5 | 5 | 5 | 5 | 5 | 5 | 3 |
| 11 | 5 | 5 | 5 | 5 | 5 | 5 | 5 | 5 | 5 | 3 |
2.3. Antimicrobial Activities
| Dye No. | Inhibition zone diameter | ||||
|---|---|---|---|---|---|
| G+ve bacteria | G-ve bacteria | Fungi | |||
| B. subtilis Mean ± SD | S. aureus Mean ± SD | E. coli Mean ± SD | P. aeruginosa Mean ± SD | C. albicans Mean ± SD | |
| 3 | 8.4 ± 0.7 | 6.6 ± 0.2 | 11.2 ± 0.2 | 8.6 ± 1.3 | - |
| 7 | - | - | - | - | - |
| 8 | - | - | - | - | - |
| 9 | 5.1 ± 0.5 | 5.1 ± 0.2 | 7.4 ± 0.8 | 6 ± 0.3 | 6.4 ± 0.4 |
| 11 | - | - | - | - | - |
| Ampicillin * | 10 ± 0.5 | 3.5 ± 0.2 | 10.8 ± 0.7 | 9.5 ± 2.6 | |
| Cycloheximide ** | - | ||||

3. Experimental
3.1. General
3.2. High Temperature Dyeing Method (HT)
3.2.1. Materials
3.2.2. Dyeing
3.3. Color Measurements and Analyses
3.3.1. Color Measurements
3.3.2. Fastness Testing
3.3.2.1. Fastness to Washing
3.3.2.2. Fastness to Perspiration
3.3.2.3. Fastness to Light
3.4. Antimicrobial Activities Test
4. Conclusions
Acknowledgments
Conflicts of Interest
References and Notes
- Towns, A.D. Developments in azo disperse dyes derived from heterocyclic diazo components. Dyes Pigm. 1999, 42, 3–28. [Google Scholar]
- Hallas, G.; Towns, A.D. Dyes derived from aminothiophenes. Part 6: Application of some nitro-substituted thiophene-based azo disperse dyes to hydrophobic fibres. Dyes Pigm. 1997, 35, 45–55. [Google Scholar]
- Maradiya, H.R.; Patel, V.S. Thiophene based monoazo disperse dyes for polyester fabric. J. Serb. Chem. Soc. 2002, 67, 17–25. [Google Scholar]
- Bhatti, H.S.; Seshadri, S. Novel disperse dyes from benzo[b]thiophene-3(2H)-one-1,1-dioxide and ethylbenzo[b]thien-3(2H)-ylidenecyanoacetate, S,S-dioxide:synthesis and properties. Dyes Pigm. 2004, 62, 83–92. [Google Scholar]
- Naik, S.J.; Halkar, U.P. Synthesis of 4,5,6,7-tetrahydrobenzo [b] thiophene based azo disperse dyes. Ind. J. Het. Chem. 2006, 15, 213–216. [Google Scholar]
- Rangnekar, D.W.; Telange, V.R. Synthesis of novel thieno[2,3-b]thiophene based bisazo disperse dyes. J. Ind. Coun. Chem. 2000, 17, 11–14. [Google Scholar]
- Maradiya, H.R.; Patel, V.S. Synthesis of 2-azobenzo[b]thiophene derivatives and their application on nylon fibre. Chem. Heterocycl. Compd. 2002, 38, 281–286. [Google Scholar]
- Afifi, T.H. One-bath dyeing of polyester/wool blend using azo dyes derived from 2-aminothiophenes. Advan. Col. Sci. Tech. 2003, 6, 63–72. [Google Scholar]
- Abd-El-Aziz, A.S.; Afifi, T.H. Novel azo disperse dyes derived from aminothiophenes: Synthesis and UV-visible studies. Dyes Pigm. 2006, 70, 8–17. [Google Scholar]
- Al-Mousawi, S.; Elassar, A-Z.; El-Apasery, M.A. A microwave assisted diazo coupling reaction: the synthesis of alkyl azines and thienopyridazines. Phosphorus, Sul. Sil. Rel. Elem. 2006, 181, 1755–1771. [Google Scholar]
- Al-Mousawi, S.M.; El-Apasery, M.A.; Al-Kandery, N.; Elnagdi, M.H. Synthesis of 3-arylazo-6-oxopyridazine-5-carbonitriles: A versatile precursor for condensed arylazopyridazin-6-ones. J. Het. Chem. 2008, 45, 359–364. [Google Scholar]
- Al-Mousawi, S.M.; EL-Apasery, M.A.; Elnagdi, M.H. Studies with condensed aminothiophenes: microwave assisted cycloaddition reactions of thieno[3,4-d]pyridazinone and thieno[3,4-c]quinolinone. Heterocycl. 2008, 75, 1151–1161. [Google Scholar]
- Crystallographic data for the structures of compounds 4 and 8 reported in this paper have been deposited with the Cambridge Crystallographic Data Centre as supplementary publications Nos. CCDC 941638 and 941639. These data can be obtained free of charge from the Cambridge Crystallographic Data Centre. Available online: http://www.ccdc.cam.ac.uk.
- Al-Etaibi, A.M.; El-Apasery, M.A.; Ibrahim, M.R.; Al-Awadi, N.A. A facile synthesis of new monoazo disperse dyes derived from 4-hydroxyphenylazopyrazole-5-amines: evaluation of microwave assisted dyeing behavior. Molecules 2012, 17, 13891–13909. [Google Scholar]
- Chipalkatti, H.R.; Desai, N.F.; Giles, C.H.; Macaulay, N. The influence of the substrate upon the light fading of azo dyes. J. Soc. Dyers Colour 1954, 70, 487–501. [Google Scholar]
- Ritter, J.; Borst, H.U.; Lindner, T.; Hauser, M.; Brosig, S.; Bredereck, K.; Steiner, U.E.; Kuehn, D.; Kelemen, J.; Kramer, H.E.A. Substituent effects on triplet yields in aminoanthraquinones: Radiationless deactivation via intermolecular and intramolecular hydrogen bonding. J. Photochem. Photobiol. A Chem. 1988, 41, 227–244. [Google Scholar]
- Chrysler, L.P. Methods of Test for Color Fastness of Textiles and Leather, 7th ed.; Bradford: London, UK, 1990. [Google Scholar]
- Isaacson, D.M.; Kirschbaum, J. Assays of antimicrobial substances. In Manual of Industrial Microbiology and Biotechnology; Demain, A.L., Solomon, N.A., Eds.; ASM: Washington, DC, USA, 1986. [Google Scholar]
- Sample Availability: Samples of compounds 2–4, 7–9 and 11 are available from the authors.
© 2013 by the authors; licensee MDPI, Basel, Switzerland. This article is an open access article distributed under the terms and conditions of the Creative Commons Attribution license (http://creativecommons.org/licenses/by/3.0/).
Share and Cite
Al-Mousawi, S.M.; El-Apasery, M.A.; Mahmoud, H.M. Disperse Dyes Based on Aminothiophenes: Their Dyeing Applications on Polyester Fabrics and Their Antimicrobial Activity. Molecules 2013, 18, 7081-7092. https://doi.org/10.3390/molecules18067081
Al-Mousawi SM, El-Apasery MA, Mahmoud HM. Disperse Dyes Based on Aminothiophenes: Their Dyeing Applications on Polyester Fabrics and Their Antimicrobial Activity. Molecules. 2013; 18(6):7081-7092. https://doi.org/10.3390/molecules18067081
Chicago/Turabian StyleAl-Mousawi, Saleh Mohammed, Morsy Ahmed El-Apasery, and Huda M. Mahmoud. 2013. "Disperse Dyes Based on Aminothiophenes: Their Dyeing Applications on Polyester Fabrics and Their Antimicrobial Activity" Molecules 18, no. 6: 7081-7092. https://doi.org/10.3390/molecules18067081
APA StyleAl-Mousawi, S. M., El-Apasery, M. A., & Mahmoud, H. M. (2013). Disperse Dyes Based on Aminothiophenes: Their Dyeing Applications on Polyester Fabrics and Their Antimicrobial Activity. Molecules, 18(6), 7081-7092. https://doi.org/10.3390/molecules18067081
